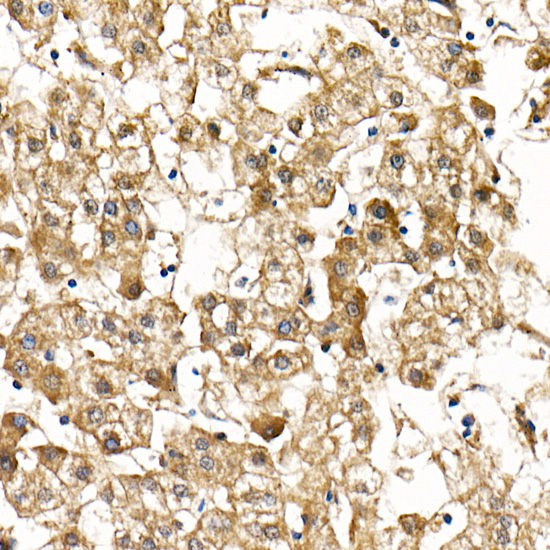
Smad9 Rabbit Polyclonal Antibody

The protein encoded by this gene is a member of the SMAD family, which transduces signals from TGF-beta family members. The encoded protein is activated by bone morphogenetic proteins and interacts with SMAD4. Two transcript variants encoding different isoforms have been found for this gene.
| Pack Size | 100ul, 1ml, 20ul |
|---|---|
| Applications | ELISA, IHC-P |
| Host Species | Rabbit |
| Ig Isotype | IgG |
| Antibody Type | Polyclonal Antibody |
| Organism Species | Human |
| Product Synonyms | Smad9 |
| Observed Mol Wt | 52kDa |
| Alternative Names | PPH2; MADH6; MADH9; SMAD8; SMAD8A; SMAD8B; SMAD8/9; Smad9 |
| Immunogen (Antigen) | Recombinant protein |
| Format | Liquid |
| Buffer Formulation | 50% glycerol, PBS with 0.05% proclin300, pH7.3 |
| Reactivity | Human, Mouse, Rat |
| Uniprot ID | 4093 |
| Gene ID | O15198 |
| Purification | Antigen-specific affinity chromatography followed by Protein A affinity chromatography |
| Usage | For Research Use Only. Not for diagnostics or human use. |
| Shelf Life | 12 months at time of shipping |
| Shipping | Shipped in Dry Ice at -20 Degree Celsius |
| Storage | Store at -20 Degree Celsius. It is recommended to aliquot and store to avoid repeated freeze-thaw as it affects the stability of the antibody. |
| Research Areas | Cancer, Cell Biology, Immunology |
| KD/KO Validated | KD Validated |
| Disclaimer | The data indicated herein are as indicated and validated in our laboratory. These reagents are for research use only and not for in-vitro diagnostics or human use. |
![CYB5R3 Rabbit Polyclonal Antibody [KD Validated]](https://www.kinesisdx.com/wp-content/uploads/2025/05/A24755_N30496-4_WB_01-370x444.jpg)
![RHOT1/MIRO1 Rabbit Polyclonal Antibody [KD Validated]](https://www.kinesisdx.com/wp-content/uploads/2025/05/A22551_N1681810-11_WB_01-370x444.jpg)
![COMT Rabbit Polyclonal Antibody [KD Validated]](https://www.kinesisdx.com/wp-content/uploads/2025/05/A23600_N27285-4_WB_01-370x444.jpg)
![EGFR Rabbit Polyclonal Antibody [KD Validated]](https://www.kinesisdx.com/wp-content/uploads/2025/05/A11576_Q722_WB_01-370x444.jpg)
![CDX2 Rabbit Polyclonal Antibody [KD Validated]](https://www.kinesisdx.com/wp-content/uploads/2025/05/A1629_MP3070-02_N14929_WB_01-370x444.jpg)
![CAT1 Rabbit Polyclonal Antibody [KD Validated]](https://www.kinesisdx.com/wp-content/uploads/2025/05/A25422_N32165-5_WB_01-370x444.jpg)
Reviews
There are no reviews yet.